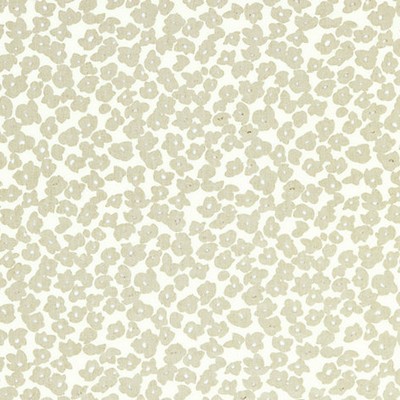
Grey Watkins OLEANA STARLIGHT

Fabric Blinds Curtain Rods Window Treatments Trims & Tassels Wallpaper
$420.00 USD per yard
Retail:$560.00
Retail:
| SKU: GW166190001 |
| Color: STARLIGHT |
| 53.5 " Wide*Metric Conversions |
| 100% LINEN |
| 37 " Horizontal Repeat |
| 13 " Vertical Repeat |
| Please note pattern features a large repeat. |
| LIGHT DUTY |
| DRY CLEAN ONLY |
| Made In SWITZERLAND |
| Multipurpose Fabric |
| LARGE Scale METALLIC FLORA Grey Watkins |
Orders are reviewed for accuracy and availability prior to payment processing.
 International Shipping Information
International Shipping Information
All prices are subject to change without notice. We reserve the right to correct pricing errors.
All shipping and special processing charges are additional. Standard US shipping times are approximately 7–14 business days unless otherwise noted above.
InteriorDecorating.com is not responsible for loss or theft after confirmed delivery by the carrier; however, we will assist customers in filing carrier claims whenever possible.
Ordering Information
Returns may be subject to restocking fees and additional category-specific conditions. See complete policy. - click here for complete policy.
Computer images may not represent color accurately. Monitor settings and lighting conditions may affect how colors appear. Product finishes and colors may vary slightly between manufacturing runs. Please review specifications carefully before ordering.
Computer images may not represent color accurately. Monitor settings and dye lot variations may affect appearance. Samples or Cutting for Approval are recommended when exact color match is required.
Please inspect fabric before cutting. Fabric that has been altered or further cut by the customer may not be eligible for return or damage claims.
We can have your fabric treated: Vinylizing - Material Backings - Stain and Antimicrobial Treatments - Fire Protection. Give us a call for a price quote.
We can ship your fabric to your drapery workroom or upholsterer - just put the correct information in the ship to address.
 International Shipping Information
International Shipping InformationAll prices are subject to change without notice. We reserve the right to correct pricing errors.
All shipping and special processing charges are additional. Standard US shipping times are approximately 7–14 business days unless otherwise noted above.
InteriorDecorating.com is not responsible for loss or theft after confirmed delivery by the carrier; however, we will assist customers in filing carrier claims whenever possible.
Ordering Information
Returns may be subject to restocking fees and additional category-specific conditions. See complete policy. - click here for complete policy.
Computer images may not represent color accurately. Monitor settings and lighting conditions may affect how colors appear. Product finishes and colors may vary slightly between manufacturing runs. Please review specifications carefully before ordering.
Computer images may not represent color accurately. Monitor settings and dye lot variations may affect appearance. Samples or Cutting for Approval are recommended when exact color match is required.
Please inspect fabric before cutting. Fabric that has been altered or further cut by the customer may not be eligible for return or damage claims.
We can have your fabric treated: Vinylizing - Material Backings - Stain and Antimicrobial Treatments - Fire Protection. Give us a call for a price quote.
We can ship your fabric to your drapery workroom or upholsterer - just put the correct information in the ship to address.
| Inches | Centimeters |
| 44 in | 111.76 cm |
| 54 in | 137.16 cm |
| 118 in | 299.72 cm |
| 1 yard = .9144 meters or 91.44 cm | |
| 1 in = 2.54 cm | |